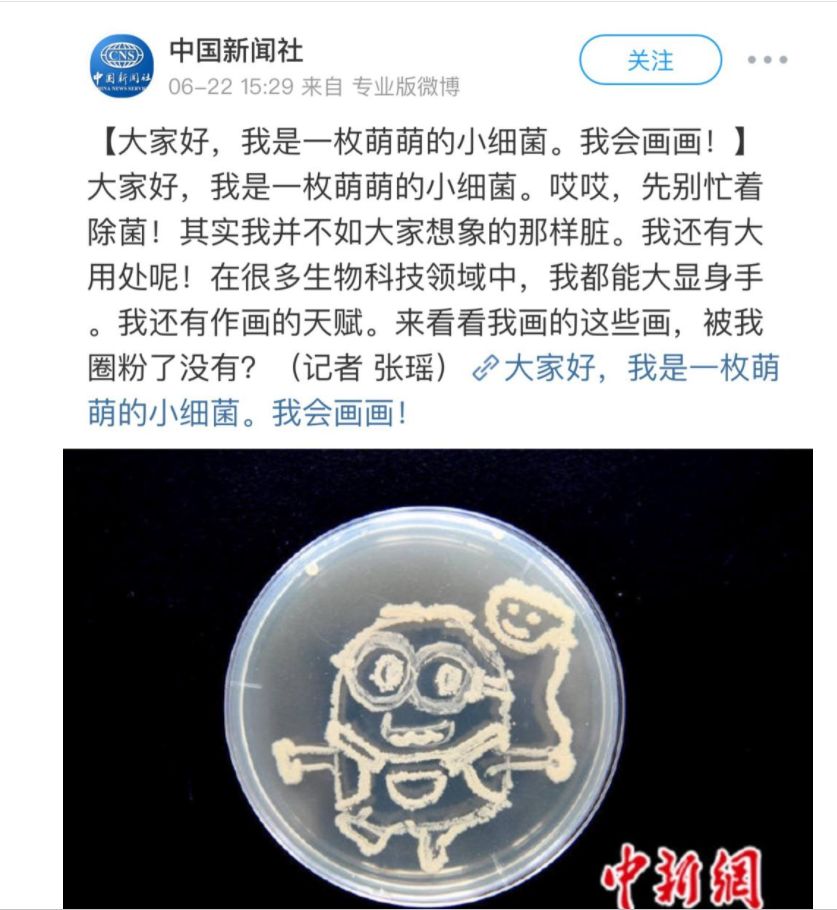
我校学子创意细菌画吸引众多媒体关注
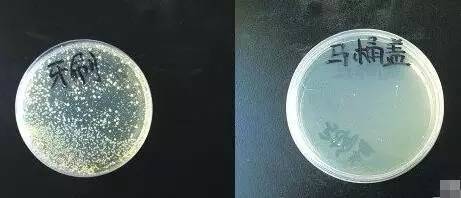
这些东西细菌真不少!一定要看!|晓得

钱上的细菌

纸币上隐藏的细菌-库存照片
图片尺寸1200x797
曲靖食药监
图片尺寸667x374
男孩拉肚子因常摸钱 医生演示纸币细菌测验(图)
图片尺寸420x280
摸钱的瞬间,你经历了一次3000多种细菌大迁徙
图片尺寸615x409
一老人7万元纸币发霉成纸疙瘩银行温馨提醒客户
图片尺寸1080x1439
还有网友称纸币上部分图像如同显微镜下细菌的样子.
图片尺寸489x240
一老人7万元纸币发霉成"纸疙瘩",银行温馨提醒客户_手机搜狐网
图片尺寸1080x1439
每张纸币带细菌:900万个
图片尺寸1080x810
钱霉了还能回来吗还好有
图片尺寸1080x810
人民币成细菌"天堂" 平均含菌量18万鹤立亚洲
图片尺寸450x293
广东地区纸币的细菌比别的地区多?有人摸完钱不洗手,结果得了性病?
图片尺寸626x393
我校学子创意细菌画吸引众多媒体关注
图片尺寸837x910
广东地区纸币的细菌比别的地区多?有人摸完钱不洗手,结果得了性病!
图片尺寸549x331
老农8000元"养老钱"地下埋10年变"钱渣"
图片尺寸396x289
男孩拉肚子因常摸钱 医生演示纸币细菌测验(图)
图片尺寸420x280
广东地区纸币的细菌比别的地区多?有人摸完钱不洗手,结果得了性病!
图片尺寸1280x960
这些东西细菌真不少!一定要看!|晓得
图片尺寸461x198
商丘老人将钱深埋地下,结果十万余元大钞霉变腐烂!
图片尺寸600x450
你的压岁钱有多少细菌你知道么
图片尺寸972x607
20万现金藏了3年,发霉恶臭阵阵,真数钱数到吐
图片尺寸600x800